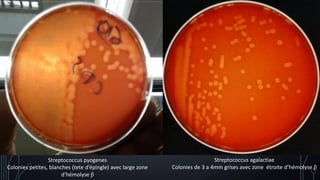
Streptococcus pyogenes
Colonies petites, blanches (tete d’épingle) avec large zone
d’hémolyse β
Streptococcus agalactiae
Colonies de 3 a 4mm grises avec zone étroite d’hémolyse β
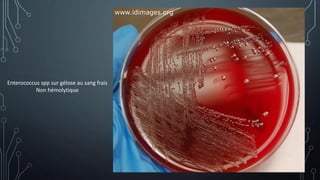
Enterococcus spp sur gélose au sang frais
Non hémolytique
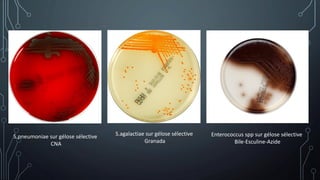
S.pneumoniae sur gélose sélective
CNA
S.agalactiae sur gélose sélective
Granada
Enterococcus spp sur gélose sélective
Bile-Esculine-Azide
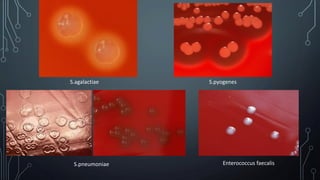
S.pneumoniae
S.agalactiae S.pyogenes
Enterococcus faecalis
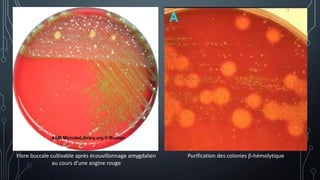
Flore buccale cultivable après écouvillonnage amygdalien
au cours d’une angine rouge
Purification des colonies β-hémolytique
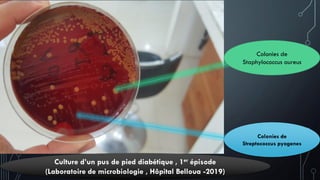
Colonies de
Staphylococcus aureus
Colonies de
Streptococcus pyogenes
Culture d’un pus de pied diabétique , 1er épisode
(Laboratoire de microbiologie , Hôpital Belloua -2019)
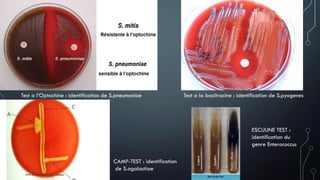
Test a l’Optochine : identification de S.pneumoniae Test a la bacitracine : identification de S.pyogenes
CAMP-TEST : identification
de S.agalactiae
ESCULINE TEST :
identification du
genre Enterococcus

Le document présente une étude approfondie sur les streptocoques, incluant leur définition, classification, caractéristiques bactériologiques, facteurs de virulence et pouvoir pathogène. Il souligne l'importance de ces bactéries dans diverses infections humaines, en particulier Streptococcus pyogenes, et aborde également la sensibilité aux antibiotiques ainsi que les méthodes de diagnostic et de prévention disponibles. Enfin, le texte décrit des infections causées par ces bactéries, allant de conditions bénignes à des maladies graves et potentiellement mortelles.